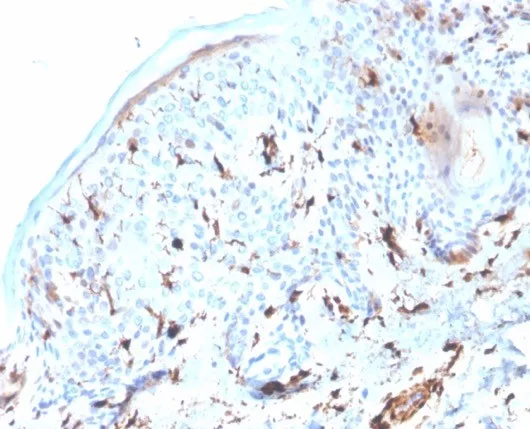

Formalin-fixed, paraffin-embedded human lung adenocarcinoma stained with S100A4 Mouse Monoclonal Antibody (S100A4/6995). Inset: PBS instead of primary antibody; secondary only negative control.
Formalin-fixed, paraffin-embedded human skin stained with S100A4 Mouse Monoclonal Antibody (S100A4/6995). HIER: Tris/EDTA, pH9.0, 45min. 2°C: HRP-polymer, 30min. DAB, 5min.

Analysis of Protein Array containing more than 19,000 full-length human proteins using S100A4 Mouse Monoclonal Antibody (S100A4/6995). Z- and S- Score: The Z-score represents the strength of a signal that a monoclonal antibody (MAb) (in combination with a fluorescently-tagged anti-IgG secondary antibody) produces when binding to a particular protein on the HuProtTM array. Z-scores are described in units of standard deviations (SD's) above the mean value of all signals generated on that array. If targets on HuProtTM are arranged in descending order of the Z-score, the S-score is the difference (also in units of SD's) between the Z-score. S-score therefore represents the relative target specificity of a MAb to its intended target. A MAb is considered to specific to its intended target, if the MAb has an S-score of at least 2.5. For example, if a MAb binds to protein X with a Z-score of 43 and to protein Y with a Z-score of 14, then the S-score for the binding of that MAb to protein X is equal to 29.
S100A4 belongs to the S100 super-family of proteins containing 2 EF-hand calcium-binding domains. S100 genes include at least 25 members, including S100A1-S100A18, trichohyalin, filaggrin, repetin, S100P, and S100Z. S100A4 exerts its function via direct interaction with a number of proteins including P53, P63, non-muscle myosin IIA, α6β4 integrin, and liprin b1. S100A4 is overexpressed in highly metastatic cancers, which makes it useful as a marker of tumor progression.
There are no reviews yet.